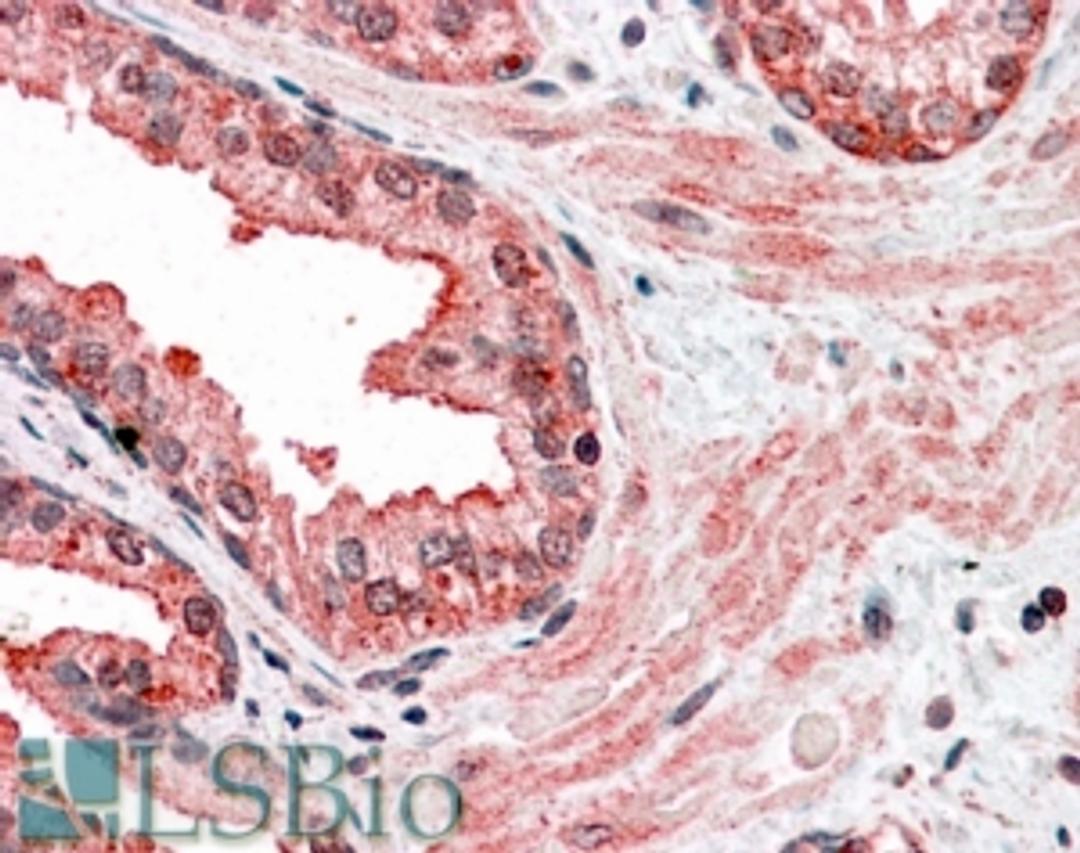

Product & ReviewsAntibodies
GCIP Antibody
Product Details
- Cat. No.
- 45-660
- Type
- Primary Antibody
- Clonality
- Polyclonal
- Host
- Goat

The supplier does not provide quotations for this antibody through SelectScience. You can search for similar antibodies in our Antibody Directory.
Description
GCIP Antibody raised in Goat validated in E, IHC in Human.
Biological Information
- Clonality: Polyclonal
- Host: Goat
- Conjugate: Unconjugated
Handling
- Quantity: 0.1 mg
- Storage: Aliquot and store at -20˚C. Minimize freezing and thawing.
- Buffer: Supplied at 0.5 mg/ml in Tris saline, 0.02% sodium azide, pH7.3 with 0.5% bovine serum albumin. Aliquot and store at -20°C. Minimize freezing and thawing.